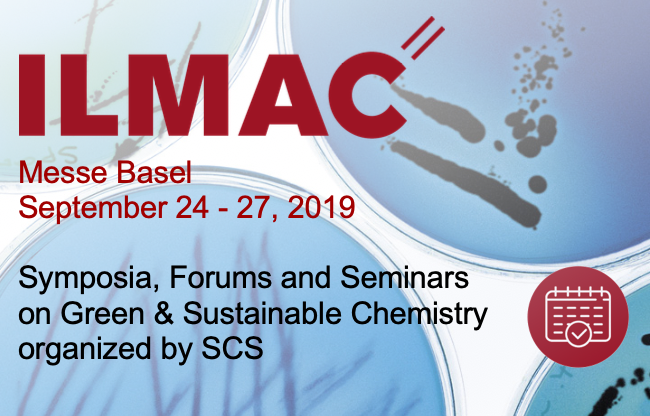

Welcome to the 2019 Fall Meeting of the Swiss Chemical Society!
We are pleased to invite you to the SCS Fall Meeting 2019, one of the largest annual research conferences held in Switzerland. We expect close to 1'000 participants representing both, industry and academia.
For generations of young chemists educated in Switzerland, the Fall Meeting has been a great platform to present their research –often for the first time ever at a major conference- and to be inspired by the people you get to meet.
The Scientific Program offers Award Lectures presented by leaders in their respective fields, as well as invited and contributed lectures in eight thematic sessions. For each of these, there also is a poster session. All in all, we expect about 600 scientific presentations.
Detailed session programs including links to abstracts:
- Analytical Sciences
- Catalysis Science & Engineering
- Computational Chemistry
- Inorganic & Coordination Chemistry
- Medicinal Chemistry & Chemical Biology
- Organic Chemistry
- Physical Chemistry
- Polymers, Colloids & Interfaces
![]() Search all abstracts (lectures, talks and posters) -> This option is for registered participants only. Please log in to your profile first.
Search all abstracts (lectures, talks and posters) -> This option is for registered participants only. Please log in to your profile first.
![]() Download pdf files per session and presentation type. This option is for registered participants only. Please log in to your profile first.
Download pdf files per session and presentation type. This option is for registered participants only. Please log in to your profile first.
Finally, the best student oral and poster-presentations of each session will be awarded prizes. The SCS Metrohm and DSM Award Programs are among the most highly remunerated, and the Award Ceremony at the end of the meeting marks one of the highlights of the event.
We encourage you to come to Zurich to present your research and to be part of a vibrant meeting. We look forward to seeing you!
Prof. Roger Alberto, University of Zürich / DFR President, and
Dr. Hans Peter Lüthi, ETH Zürich / SCS Foundation (Fall Meeting co-Chairs)
Dr. Alain De Mesmaeker, Syngenta, SCS President
Mr. David Spichiger, SCS Executive Director
Photos of the SCS Fall Meeting 2019
- Dinner in the Zunfthaus zur Waag, September 5, 2019
- Best Oral Presentation Award Ceremony
- Best Poster Presentation Award Ceremony
- Ceremony of the SCS Helvetica Prize 2019
- Laureates speakers
- Invited speakers and short talk speakers
- Winners of the Exhibitor Challenge
- General conference picrures and exhibition
Photos: H.P. Lühti, SCS